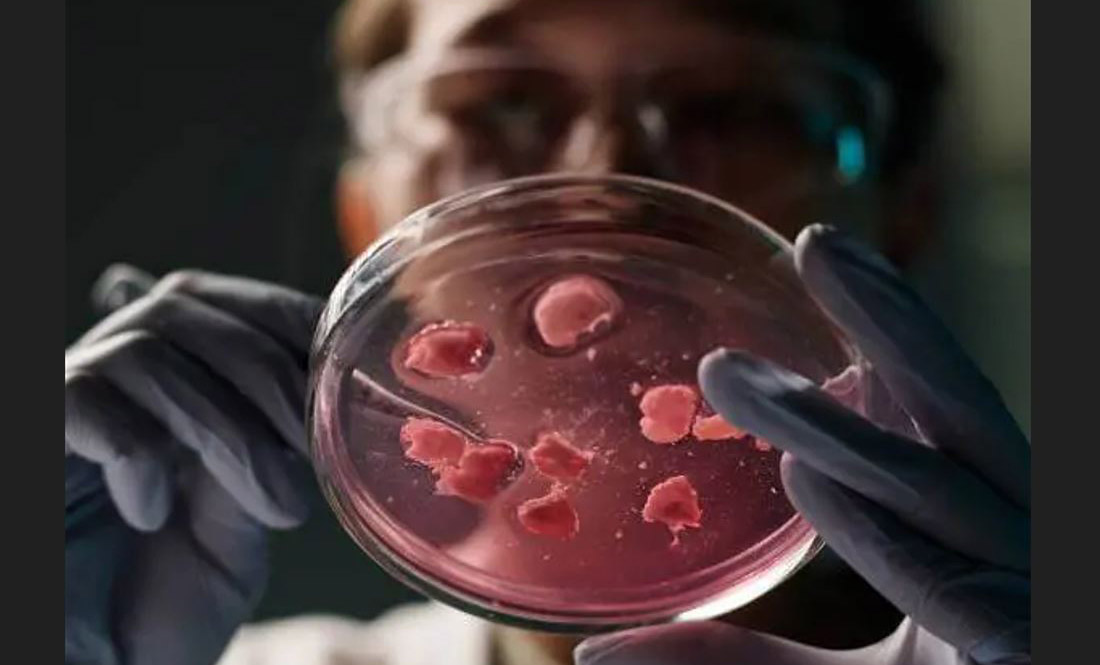

« Le mot est un être vivant et très difficile à manier. Il faut le conquérir. On ne le conquiert pas sans souffrance, sans effort, sans y mettre son âme. » Léon Tolstoï, Carnets.
On ne badine pas avec les mots. Qui n’a jamais ressenti l’angoisse de la page blanche, ce moment suspendu où les mots se dérobent, vous fuient, ou au contraire affluent en cohue, comme un fouillis si dense que même la pensée la plus claire peine à s’y frayer un chemin ?
Expert en édition de contenu pour les associations, institutions et entreprises, je suis à votre disposition afin de rédiger et mettre en forme vos supports de communication et projets pédagogiques.